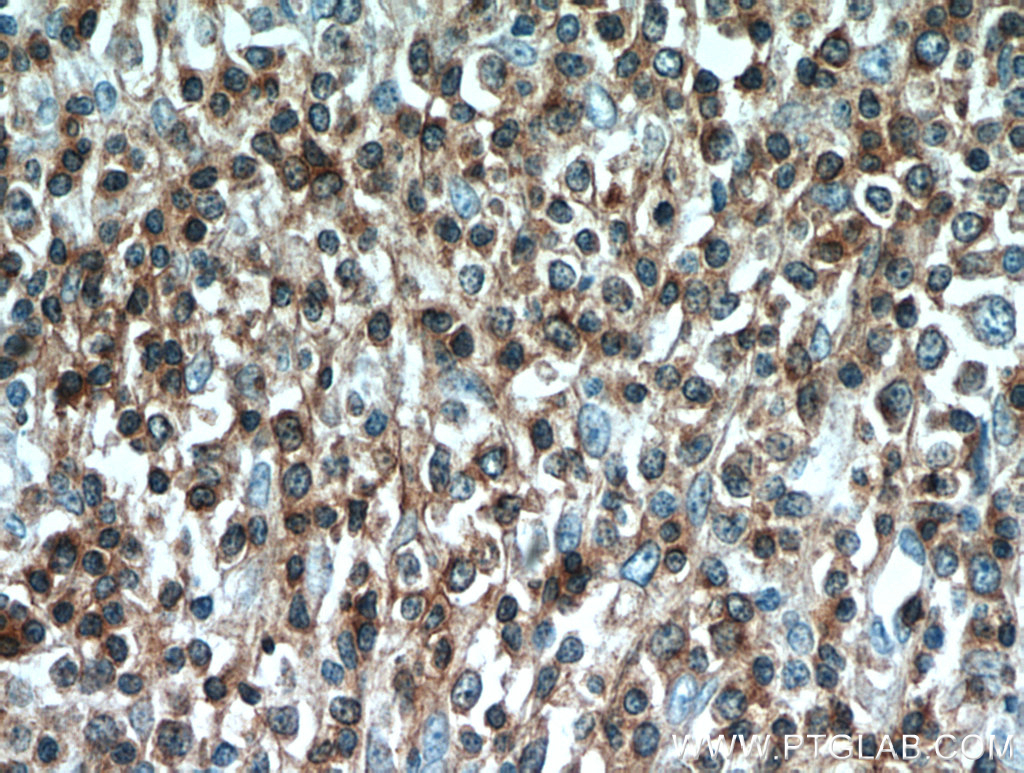
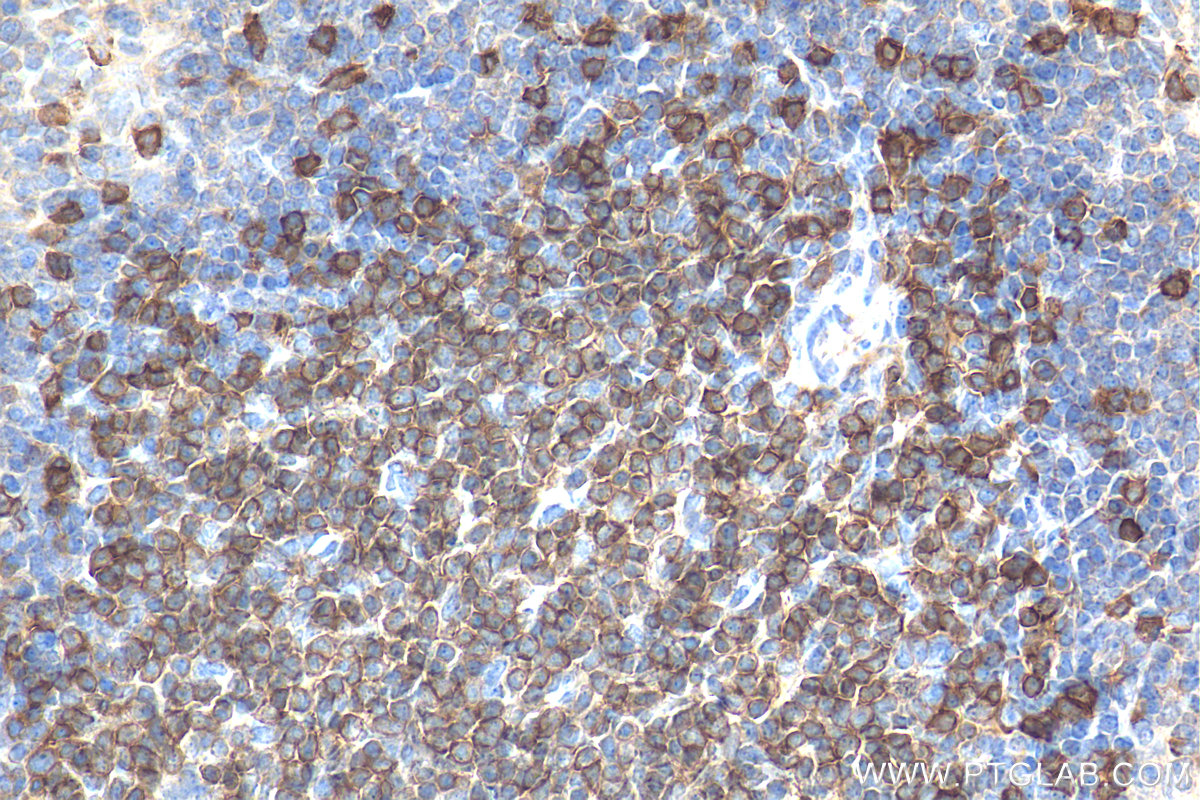

验证数据展示
经过测试的应用
| Positive WB detected in | Jurkat cells, pig spleen tissue, MOLT-4 cells, mouse thymus tissue, rat thymus tissue |
| Positive IP detected in | Jurkat cells |
| Positive IHC detected in | human tonsillitis tissue, mouse spleen tissue, human lymphoma tissue, human lung cancer tissue, human breast cancer tissue, mouse colon tissue, human pancreas cancer tissue, rat thymus tissue Note: suggested antigen retrieval with TE buffer pH 9.0; (*) Alternatively, antigen retrieval may be performed with citrate buffer pH 6.0 |
| Positive IF-P detected in | human tonsillitis tissue, mouse spleen tissue |
| Positive IF-Fro detected in | mouse spleen tissue |
推荐稀释比
| 应用 | 推荐稀释比 |
|---|---|
| Western Blot (WB) | WB : 1:20000-1:100000 |
| Immunoprecipitation (IP) | IP : 0.5-4.0 ug for 1.0-3.0 mg of total protein lysate |
| Immunohistochemistry (IHC) | IHC : 1:500-1:2000 |
| Immunofluorescence (IF)-P | IF-P : 1:50-1:500 |
| Immunofluorescence (IF)-FRO | IF-FRO : 1:50-1:500 |
| It is recommended that this reagent should be titrated in each testing system to obtain optimal results. | |
| Sample-dependent, Check data in validation data gallery. | |
产品信息
17617-1-AP targets CD3 in WB, IHC, IF-P, IF-Fro, IP, ELISA, Cell treatment applications and shows reactivity with human, mouse, rat, pig samples.
| 经测试应用 | WB, IHC, IF-P, IF-Fro, IP, ELISA Application Description |
| 文献引用应用 | WB, IHC, IF, Cell treatment |
| 经测试反应性 | human, mouse, rat, pig |
| 文献引用反应性 | human, mouse, rat, pig |
| 免疫原 |
CatNo: Ag11797 Product name: Recombinant human CD3E protein Source: e coli.-derived, PET28a Tag: 6*His Domain: 1-207 aa of BC049847 Sequence: MQSGTHWRVLGLCLLSVGVWGQDGNEEMGGITQTPYKVSISGTTVILTCPQYPGSEILWQHNDKNIGGDEDDKNIGSDEDHLSLKEFSELEQSGYYVCYPRGSKPEDANFYLYLRARVCENCMEMDVMSVATIVIVDICITGGLLLLVYYWSKNRKAKAKPVTRGAGAGGRQRGQNKERPPPVPNPDYEPIRKGQRDLYSGLNQRRI 种属同源性预测 |
| 宿主/亚型 | Rabbit / IgG |
| 抗体类别 | Polyclonal |
| 产品类型 | Antibody |
| 全称 | CD3e molecule, epsilon (CD3-TCR complex) |
| 别名 | CD3E, CD3 Epsilon, CD3-epsilon, T3E, T-cell surface antigen T3/Leu-4 epsilon chain |
| 计算分子量 | 207 aa, 23 kDa |
| 观测分子量 | 23-25 kDa |
| GenBank蛋白编号 | BC049847 |
| 基因名称 | CD3 |
| Gene ID (NCBI) | 916 |
| ENSEMBL Gene ID | ENSG00000198851 |
| RRID | AB_1939430 |
| 偶联类型 | Unconjugated |
| 形式 | Liquid |
| 纯化方式 | Antigen affinity purification |
| UNIPROT ID | P07766 |
| 储存缓冲液 | PBS with 0.02% sodium azide and 50% glycerol, pH 7.3. |
| 储存条件 | Store at -20°C. Stable for one year after shipment. Aliquoting is unnecessary for -20oC storage. |
背景介绍
CD3 is a complex of proteins that directly associates with the T cell receptor (TCR). The TCR/CD3 complex of T-lymphocytes consists of either a TCR alpha/beta or TCR gamma/delta heterodimer coexpressed at the cell surface with the invariant subunits of CD3 labeled gamma, delta, epsilon, zeta, and eta. The TCR recognizes antigens bound to major histocompatibility complex (MHC) molecules. TCR-mediated peptide-MHC recognition is transmitted to the CD3 complex, leading to the intracellular signal transduction. CD3 is considered to be a pan-T cell marker for detection of normal and neoplastic T cells. This anti-CD3 is a polyclonal antibody directed against the epsilon chain of human CD3 molecule.
实验方案
| Product Specific Protocols | |
|---|---|
| IF protocol for CD3 antibody 17617-1-AP | Download protocol |
| IHC protocol for CD3 antibody 17617-1-AP | Download protocol |
| IP protocol for CD3 antibody 17617-1-AP | Download protocol |
| WB protocol for CD3 antibody 17617-1-AP | Download protocol |
| Standard Protocols | |
|---|---|
| Click here to view our Standard Protocols |
发表文章
| Species | Application | Title |
|---|---|---|
Blood C1Q labels a highly aggressive macrophage-like leukemia population indicating extramedullary infiltration and relapse | ||
Nat Commun Engineered triple inhibitory receptor resistance improves anti-tumor CAR-T cell performance via CD56. | ||
J Adv Res Zearalenone-14-glucoside specifically promotes dysplasia of Gut-Associated Lymphoid Tissue: A natural product for constructing intestinal nodular lymphatic hyperplasia model | ||
J Immunother Cancer Hypoxia upregulates the expression of PD-L1 via NPM1 in breast cancer | ||
Cancer Res M6A Demethylase ALKBH5 Regulates PD-L1 Expression and Tumor Immunoenvironment in Intrahepatic Cholangiocarcinoma. |